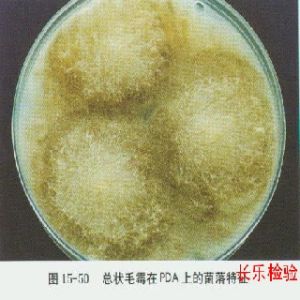
總狀毛霉 總狀毛霉

拉丁綱名 Phycomycetes
中文綱名 藻狀菌綱
拉丁目名 Mucorales
中文目名 毛霉目
拉丁科名 Mucoraceae
中文科名 毛霉科
拉 丁 名 Mucor racemosus
中 文 名 總狀毛霉
定 名 人 Fres.
參考文獻 Mucoraceae
采 集 地 河北 (141,184),山西 (184),內蒙古 (184),吉林 (184,282),黑龍江 (184),陝西 (184),甘肅 (184),寧夏 (184),青海 (184),新疆 (184),山東 (184),江蘇 (184),浙江 (184),安徽 (184),江西 (184),福建 (184),河南 (184),湖北 (184),湖南 (184),廣東 (184),廣西 (184),四川 (13,40,184),貴州 (184),雲南 (184),西藏 (145)
相關詞條
-
毛霉
毛霉又叫黑霉、長毛霉,是接合菌門,接合菌綱,毛霉目,毛霉科真菌中的一個大屬。毛霉以孢囊孢子和接合孢子繁殖,在土壤、糞便、禾草及空氣等環境中存在。
簡介 生長環境 用途 作用 -
香菇毛霉
菌絲體上直接生出單生、總狀分枝或假軸狀分枝的孢囊梗。 囊內產大量球形、橢圓形、壁薄、光滑的孢囊孢子。 毛黴菌絲初期白色,後灰白色至黑色,這說明孢子囊大量成熟。
簡介 生存環境 -
毛黴菌
脂肪酶、果膠酶、凝乳酶等。常用的毛霉主要有魯氏毛霉和總狀毛霉。腐生,廣泛...其澱粉酶制曲、釀酒;利用其蛋白酶以釀製腐乳、豆豉等。代表種如總狀毛霉...。不產生定形菌落。菌絲體上直接生出單生、總狀分枝或假軸狀分枝的孢囊梗。各...
外形特徵 分布及用途 引起疾病 -
皮膚毛霉病
,M.amphibiorum,M.mdicus,總狀毛霉和凍土毛霉。凍土毛霉1907年由...;PAS染色(+)。凍土毛霉所致的原發性皮膚毛霉病皮損組織病理學檢查(HE染色)患者潰瘍面焦痂下膿性分泌物直接塗片鏡檢可見粗大的菌絲凍土毛霉所致...
概述 相關搜尋 -
侵襲性肺部真菌感染
絲狀菌落,較細菌和放線菌的菌落大而質地疏鬆,呈絨毛狀、氈狀、棉絮狀,因...嗜血管性的毛霉,易侵犯血管,肺部感染時常導致肺栓塞甚至肺梗塞,似肺血栓...,由麴黴菌絲和纖維粘液混合而成,寄生在肺空洞內或囊狀擴張的支氣管內...
病原學 流行病學 臨床表現 疾病防治策略 侵襲性肺麴黴病(IPA) -
豆製品發酵微生物
是根霉或細菌),如腐乳毛霉、魯氏毛霉和總狀毛霉等。毛霉的生長大致分為孢子...疾病的記載。國內外豆豉按制曲時參與的微生物不同,可以分為毛霉型、麴黴型、根霉型和細菌型等。毛霉型以重慶的“永川豆豉”為代表; “瀏陽豆豉”是以麴黴...
營養價值 微生物作用 活性及功能 -
現代醫學真菌檢驗手冊
沃爾夫被孢霉6.11共頭霉屬6.11.1總狀共頭霉6.12 蟲霉目真菌...鑑定試驗6.1.3各論6.2毛霉目真菌6.2.1概論6.2.2各論6.3根霉屬6.3.1匍枝根霉6.3.2少根根霉6.3.3同親根霉6.3.4須狀...
內容介紹 作品目錄 -
真菌
掌狀,霜黴菌為絲狀,鏽菌為指狀,白鏽菌為小球狀。有些真菌的菌絲體生長到...綠豆、鼠糞或不規則狀。子座是由菌絲在寄主表面或表皮下交織形成的一種墊狀結構...不良環境的作用。菌索是由菌絲體平行組成的長條形繩索狀結構,外形與植物的根...
定義 兩大結構 繁殖方式 起源和演化 系統分類